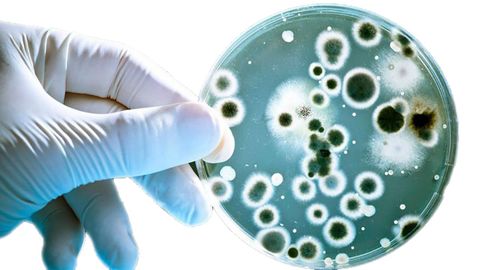
Determinados microorganismos est�n asociados a la fatiga mental o f�sica

Los veterinarios reivindican en Madrid que se les considere sanitarios al grito de «sin inspección, no hay chuletón»
En torno a un millar de personas llegadas de toda España reclamaron en Madrid que se les aplique el IVA correspondiente a un trabajador de la salud